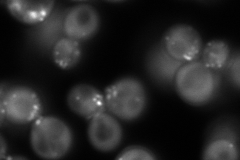
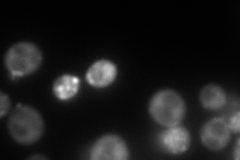
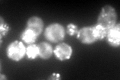

View description
Fimbrin, actin-bundling protein; cooperates with Scp1p (calponin/transgelin) in the organization and maintenance of the actin cytoskeleton
Localization:
Intensity:
Fold change:
Significance:
-
C’ GFP library in SD

punctate245.53 -
N' NOP1pr-GFP in SD
punctate,bud neck361.766 -
N' TEF2pr-mCherry in SD
punctate,bud neck213.832 -
N' NATIVEpr-GFP in SD

punctate,bud neck81.1734 -
N' TEF2pr-VC and Cyto-VN in SD

cytosol70.2945 -
C’ GFP library in SD+DTT

punctate469.551.91Yes -
C’ GFP library in SD+H2O2
punctate312.581.27No -
C’ GFP library in Starvation Media

punctate311.41.26No -
C’ GFP library on the background of Pup2-DaMP

punctate -
C’ GFP library on the background of CCT mutant

punctate274.1651.11659No
